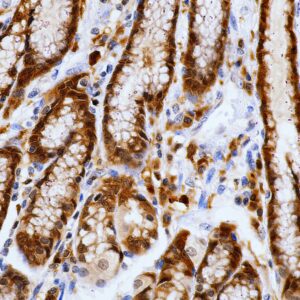
AMB42

C
Showing 101–120 of 234 resultsSorted by latest
-

Anti-CD41/Integrin
Read more -

Anti-CD41/Integrin
Price range: $250.00 through $1,475.00 Select options This product has multiple variants. The options may be chosen on the product page -

Anti-Cytokeratin 5 + Cytokeratin 14
Price range: $250.00 through $1,105.00 Select options This product has multiple variants. The options may be chosen on the product page -

Anti-CD19
Price range: $325.00 through $1,265.00 Select options This product has multiple variants. The options may be chosen on the product page -

Anti-CD4
Price range: $325.00 through $2,419.00 Select options This product has multiple variants. The options may be chosen on the product page -

Anti-CD48
Read more -

Anti-CD48
Price range: $250.00 through $995.00 Select options This product has multiple variants. The options may be chosen on the product page -

Anti-CD63
Price range: $325.00 through $995.00 Select options This product has multiple variants. The options may be chosen on the product page -

Anti-CD79a
Price range: $325.00 through $1,830.00 Select options This product has multiple variants. The options may be chosen on the product page -

Anti-Claudin-5
Price range: $325.00 through $939.00 Select options This product has multiple variants. The options may be chosen on the product page -

Anti-Cytokeratin 4
Price range: $385.00 through $1,429.00 Select options This product has multiple variants. The options may be chosen on the product page -

Anti-CD146
Price range: $325.00 through $995.00 Select options This product has multiple variants. The options may be chosen on the product page -

Anti-Cathepsin K(CTSK/2791)
Price range: $269.00 through $979.00 Select options This product has multiple variants. The options may be chosen on the product page -
![Anti-CD4 [rCD4/3930]](https://biogenex.seosmo.click/wp-content/uploads/2021/10/AMB99-300x300.jpg)
Anti-CD4 [rCD4/3930]
Price range: $269.00 through $1,430.00 Select options This product has multiple variants. The options may be chosen on the product page -

Anti-CDK4, Clone [DCS-35]
Price range: $269.00 through $1,549.00 Select options This product has multiple variants. The options may be chosen on the product page -

Anti-CD57, Clone NK/804
Price range: $269.00 through $1,319.00 Select options This product has multiple variants. The options may be chosen on the product page -
![Anti-Cytokeratin , Clone [CAM 5.2]](https://biogenex.seosmo.click/wp-content/uploads/2021/10/CAM5.2_AMB50-300x300.jpg)
Anti-Cytokeratin , Clone [CAM 5.2]
Price range: $269.00 through $1,449.00 Select options This product has multiple variants. The options may be chosen on the product page -
Anti-Caspase-3, Clone 31A1067
Price range: $269.00 through $1,289.00 Select options This product has multiple variants. The options may be chosen on the product page -

Anti- Clusterin, Clone A-9
Price range: $269.00 through $1,105.00 Select options This product has multiple variants. The options may be chosen on the product page -

Anti-Claudin-4, Clone A-12
Price range: $269.00 through $1,305.00 Select options This product has multiple variants. The options may be chosen on the product page

